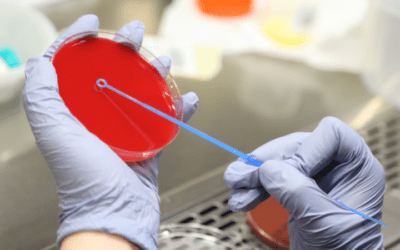
Método de identificación bacteriana en el entorno clínico actual

Escuela Online de Química, Física y Biología
Amplía tu carrera profesional en el Instituto Europeo de Química, Física y Biología
Escuela online especializada en programas formativos del ámbito de la química, física y biología, con un gran catálogo de cursos online de carácter científico, tecnológico y/o técnico. En el Instituto Europeo de Química, Física y Biología podrás estudiar online gracias a su metodología de estudio totalmente flexible y adaptada a las necesidades de cada alumno. Durante la formación todo el alumnado tendrá el apoyo y supervisión de un tutor personal que le guiará y asesorará durante toda la estancia formativa.
Encuentra el curso que estás buscando:
- ¡Oferta!

Auxiliar de Laboratorio Clínico y Químico
El precio original era: 2.380,00€.595,00€El precio actual es: 595,00€. - ¡Oferta!

Certificación Superior en Ensayos Biotecnológicos
El precio original era: 1.520,00€.380,00€El precio actual es: 380,00€. - ¡Oferta!

Certificación Superior en Laboratorio Clínico
El precio original era: 2.380,00€.595,00€El precio actual es: 595,00€. - ¡Oferta!

Especialista en Biología Molecular y Citogenética
El precio original era: 1.520,00€.380,00€El precio actual es: 380,00€. - ¡Oferta!

Experto en Análisis de Muestras en el Laboratorio de Microbiología
El precio original era: 2.380,00€.595,00€El precio actual es: 595,00€. - ¡Oferta!

Máster en Análisis Bioquímico
El precio original era: 2.380,00€.595,00€El precio actual es: 595,00€. - ¡Oferta!

Máster en Análisis Químico
El precio original era: 1.780,00€.890,00€El precio actual es: 890,00€. - ¡Oferta!

Máster en Análisis Químico + Máster en Calidad en Laboratorios
El precio original era: 1.780,00€.890,00€El precio actual es: 890,00€.
Los números hablan por nosotros
Cursos Online de Química, Física y Biología
Alumnos
Salidas profesionales
Escuela Online para especializarte en Química, Física o Biología
Si quieres conciliar tus estudios con tu vida laboral y personal, descubre la oferta formativa de Instituto Europeo de Química, Física y Biología. Encontrarás más de 70 cursos especializados en el ámbito científico. Estudia a tu ritmo y conviértete en un profesional de las ciencias y la física.
Nuestro catálogo formativo ofrece una gran variedad de titulaciones especializadas en las distintas áreas de la ciencia: biología, física o química. Disponemos de certificaciones superiores de bioquímica hasta cursos especializados en laboratorio clínico.
En el Instituto Europeo de Química, Física y Biología podrás elegir entre estudiar online o a distancia según tus preferencias y necesidades personales. Las dos metodologías son flexibles y te permitirán estudiar a tu ritmo, pudiendo conciliar tus estudios con tu vida laboral y personal.
Las titulaciones relacionadas con la química, física y biología ofrecen un sinfín de salidas profesionales en el ámbito de las ciencias ambientales, biotecnología, laboratorio clínico, entre otros muchos sectores.
Solicita información:
Diagnóstico molecular: qué es, qué detecta y qué enfermedades aborda
Si trabajas en laboratorio clínico, investigación biomédica o en entorno sanitario, entender el diagnóstico molecular ya no es opcional. Esta metodología ha transformado la forma en que se identifican las enfermedades y se interpretan procesos biológicos con un nivel...
Método de identificación bacteriana en el entorno clínico actual
El método de identificación bacteriana es una herramienta fundamental dentro del ámbito sanitario y de laboratorio, ya que permite reconocer y diferenciar microorganismos responsables de múltiples procesos infecciosos. En este blog hablaremos de los principales...
Medios de cultivo microbiológico: tipos, funciones y usos principales
Los medios de cultivo microbiológico son herramientas fundamentales para el estudio y análisis de microorganismos en distintos contextos científicos y sanitarios. En este blog hablaremos de qué son, para qué se utilizan, cuáles son los más comunes en microbiología y...
«El máster en Microbiología clínica me ha parecido bastante completo en cuanto a teoría. El temario es ameno, fácil de comprender e instructivo. Me ha servido para reforzar mis conocimientos. Por otro lado, en cuanto a los tutores, resuelven todas las dudas planteadas. ¡Excelente todo!»
«Lo más destacado del curso es el contenido didáctico ya que es muy interesante al igual que los webinars.»
«Un curso muy completo. Excelente para personas que trabajan ya que puedes organizar tus tiempos. El apoyo de la tutora excelente. En general muy contenta con la experiencia, esperando encontrar una oportunidad para desarrollar lo aprendido. Gracias.»